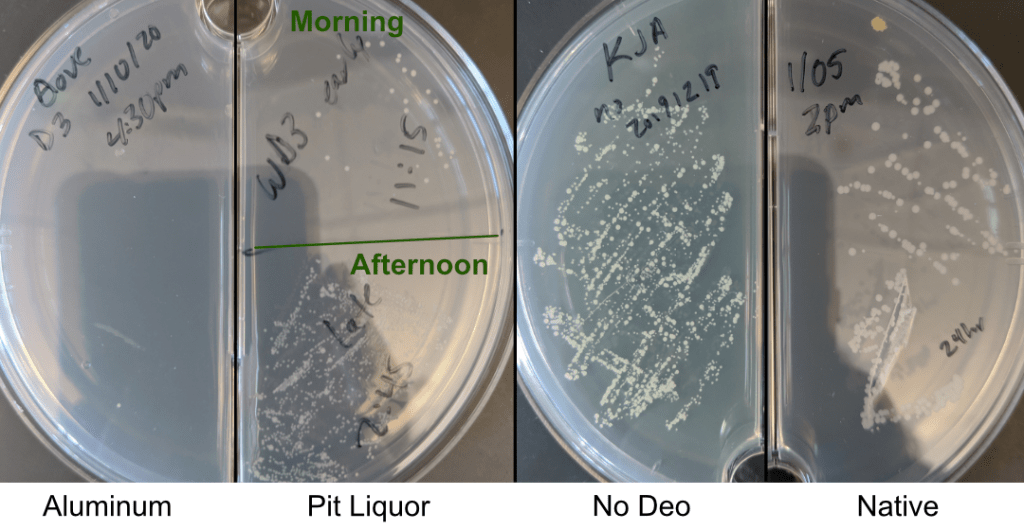
Armpit bacteria that grew over the course of the day, in different deodorant conditions.

This winter I went on a journey – a smelly journey of self-discovery – and ended up in a warehouse in Fort Collins with a toddler, a Great Dane, and underarms smelling of whiskey and girl scout cookies.
I have sensitive skin. The kind of skin that breaks out into a rash if I wear colored socks or roll down a grassy hill. This sensitivity extends to my underarms, which itch like the dickens when I use antiperspirant. And I’m not alone! In an article in The Journal of the American Medical Association Dermatology, approximately 10% of survey respondents from regions across western Europe reported having armpit rashes. About half of those people reported that their rash was due to regular use of a personal care product.
Like many people with easily upset pits, I stopped using my antiperspirant deodorant. The relief was immediate! However, shortly after my pits stopped itching, they started to stink. As a scientist, I wanted to get to the bottom of what in my antiperspirant was making my armpits itch and understand a bit about the ingredients of increasingly-popular “natural” deodorants.
It was easy to get to the bottom of my itching. The main active ingredient in antiperspirants is aluminum. This metal clogs your pores so you don’t sweat as much. It also cuts down on body odor because the bacteria that live in your pits don’t get to snack on your delicious body juice. These aluminum-based underarm products are very effective at cutting the dampness and the stench, but for people with sensitive skin, plugged sweat glands, or aluminum allergy, it can become terribly unpleasant.

While aluminum in my pits makes my skin uncomfortable, is using an antiperspirant actually bad for you? The science says no. The natural deodorant community sometimes cites papers implicating aluminum deodorant in Alzheimer’s and breast cancer risk; however, these studies do not stand up to rigorous scrutiny. There is no conclusive evidence that using aluminum on your pits increases your risk for either of these diseases.
Another argument made against antiperspirants is that your body might not be able to sweat out toxins if your pores are clogged. It turns out that the main reason we sweat is to cool our bodies, and that elimination of toxins primarily occur in our liver, intestines, and kidneys – not our sweat glands. As far as scientists can tell, using aluminum-based antiperspirants is safe for those who do not have a sensitivity, so you can curtail your body juices with glee.
If you’re like me, however, and find using antiperspirant as unpleasant as listening to a labmate’s timer go off for infinity, you’re probably interested in the hot new aluminum-free deodorants on the market and what they use to cut your stink. Just be warned up front: these are all deodorants and not antiperspirants. There is currently no known “natural” alternative to aluminum that will stop your body from releasing sweat.
To understand how to make a good deodorant, we need to know a little bit about what makes us stinky. Our body odor comes from bacteria that live in our armpits transforming odorless molecules from our sweat into molecules that stink. The main culprits are Corynebacterium and Staphylococcus; however, the types of chemicals and the amount of stink produced by these microbes varies widely between people – probably because of differences between individuals’ microbiomes and compounds released by their apocrine, or scent, glands. To fight the stink, we therefore have two options – we either kill the bacteria that are creating the foul odors or we apply compounds that sop up the stench and moisture.
Bacteria killing
This is where my whiskey and cookie pits enter the story. This month I had the pleasure of meeting with the founders of a local aluminum-free deodorant company, Pit Liquor. Erica Feucht and her husband Jason, the founders of the company, showed me around their warehouse and workroom in Fort Collins. The company came about because Erica had been trying natural deodorant for years and, she said, “Nothing worked. And the things that worked gave me a rash, [because] I have really sensitive skin.” She told me that during her pregnancy she reached a tipping point where she sprayed hand sanitizer under her armpits out of desperation, which worked better than she anticipated. The effect actually isn’t totally surprising from a scientific standpoint, because if armpit bacteria create odor, then the hand sanitizer should kill them and prevent the odor.
One of the problems of using hand sanitizer as a permanent solution is that Erica prides herself on doing “the all-natural thing” and wanted to know that everything she was putting on her body was safe and made from nature. Also, hand sanitizer can really dry out the skin to the point of being uncomfortable.
After a lot of trial and error, they settled on a final product made of organic distilled vodka and whiskey that they buy locally, along with teas that have been used in herbal medicine for their antimicrobial properties. According to Erica, “these teas help make [our product] so that it goes from lasting four to six hours, which is what an alcohol should last, to like twelve to forty-eight”. Although there isn’t any peer-reviewed science to back this up yet, Erica and Jason have anecdotal evidence from their own testing. Also, their final product smells fantastic! My go-to scent is whiskey and black pepper.

In my use of Pit Liquor, I’ve found that the odor is kept mostly at bay as long as I administer the deodorant to my whole armpit; if I miss spots I can definitely tell. This is a little different than traditional antiperspirant because the aluminum will stay in your pores for days, making it less essential to apply carefully.
To make this endeavor a bit more scientific, Graycen Wheeler helped to develop a rigorous testing protocol for each deodorant. Throughout the day I rated the smell of deodorant and body odor, monitored my clothing and sweat-inducing activities (eg. “airplane”, “did exercise video”, “wearing a flannel”), and performed an armpit swab for bacteria that I grew on agarose plates. In this very rigorous laboratory test, application of Pit Liquor killed nearly all the bacteria when applied, but if I swabbed my armpit at the end of the day most of the bacteria had come back. I also found that the stench was mostly kept at bay, except for particularly long or sweaty days. The only caveat is that I went a week without deodorant entirely, and my average stinkiness for that week was 1.01 out of 4, compared to my Pit Liquor’s average of 0.86. Different levels of (self-reported) stinkiness may play a role in how well aluminum-free deodorants work for you.
Stench quelling
If alcoholic pits aren’t your cup of spiked tea, most aluminum-free deodorant brands on the market instead use baking soda or other smell-absorbing compounds to absorb the stench produced by the bacteria that are mostly still alive on your pits. In my use, I actually found that the baking soda did a pretty good job of stopping the stench. The only caveat is that I didn’t have a good no-body-odor positive control because I didn’t make it through two days of using aluminum antiperspirant before I broke down and washed my pits at work because they itched so bad.
Other ingredients in natural deodorants include moisturizing elements such as coconut oil or shea butter, drying agents like tapioca starch or arrowroot powder, and probiotics.
For those of you who ferment foods or eat yogurt, you might be familiar with the abundance of bacteria that live on us, inside us, and in our food. Our bodies contain approximately as many bacteria cells as human cells, although the accuracy of this estimate varies greatly between individuals, and these microbes live in a usually-happy balance with us. These resident bacteria can help us absorb nutrients and fight off bad bacteria (source), and when we take antibiotics we risk disturbing the balance of good bacteria. The idea of probiotics is that if we consume good bacteria, it can help keep our microbiome healthy. While a lot of research still needs to be done to see if ingestion of probiotics is actually helpful, the bacteria we’re ingesting from fermented foods are generally safe to eat.
One of those bacteria is Lactobacillus acidophilus, which is a common intestinal and vaginal bacterium. It also lurks in most cheese, yogurt, sauerkraut, miso, and tempeh. These bacteria are perhaps the strangest ingredient I have seen in the aluminum-free deodorant game. There is no data showing that L. acidophilus lives on skin or can even survive in that environment. There also isn’t any convincing scientific evidence that these bacteria help the host or kill the smelly armpit bacteria. While it seems totally safe to apply L. acidophilus to your pits, it is probably not actually doing much.
That being said, not every ingredient in a product has to be active for it to have an effect. While the baking soda based deodorant I tried, Native, didn’t kill my armpit bacteria, it certainly absorbed most of my body odor – with a whopping 0.08 / 4 stinkiness. The only drawback I found was that my pits always felt damp because of all the moisturizers.
All of these deodorants worked to some extent but never fully recapitulated the odor-blocking power of an aluminum-based deodorant/ antiperspirant. One interesting thing that scientists have tried is replacing one person’s armpit bacteria with a less stinky person’s bacteria, which worked shockingly well, but please do not try this at home! For now, we’ll have to stick with exploring the deodorant options in our supermarkets and online stores. As a final note: Everyone’s pits are different, and you should find what works best for you. Consider this article as a science experiment that may prompt you to go on your own bacteria killing, stench quelling quest.
Update: After self-isolating for over a month and cultivating a healthy new growth of armpit hair, I stand by this article, but am re-thinking my aversion to shaving.
